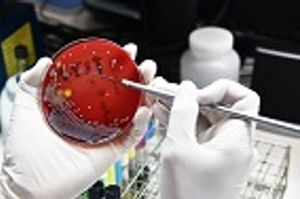

The pharmaceutical industry plays an essential role in advancing antimicrobial stewardship and addressing the growing threat of resistant pathogens.

The pharmaceutical industry plays an essential role in advancing antimicrobial stewardship and addressing the growing threat of resistant pathogens.
Published: August 12th 2020 | Updated: